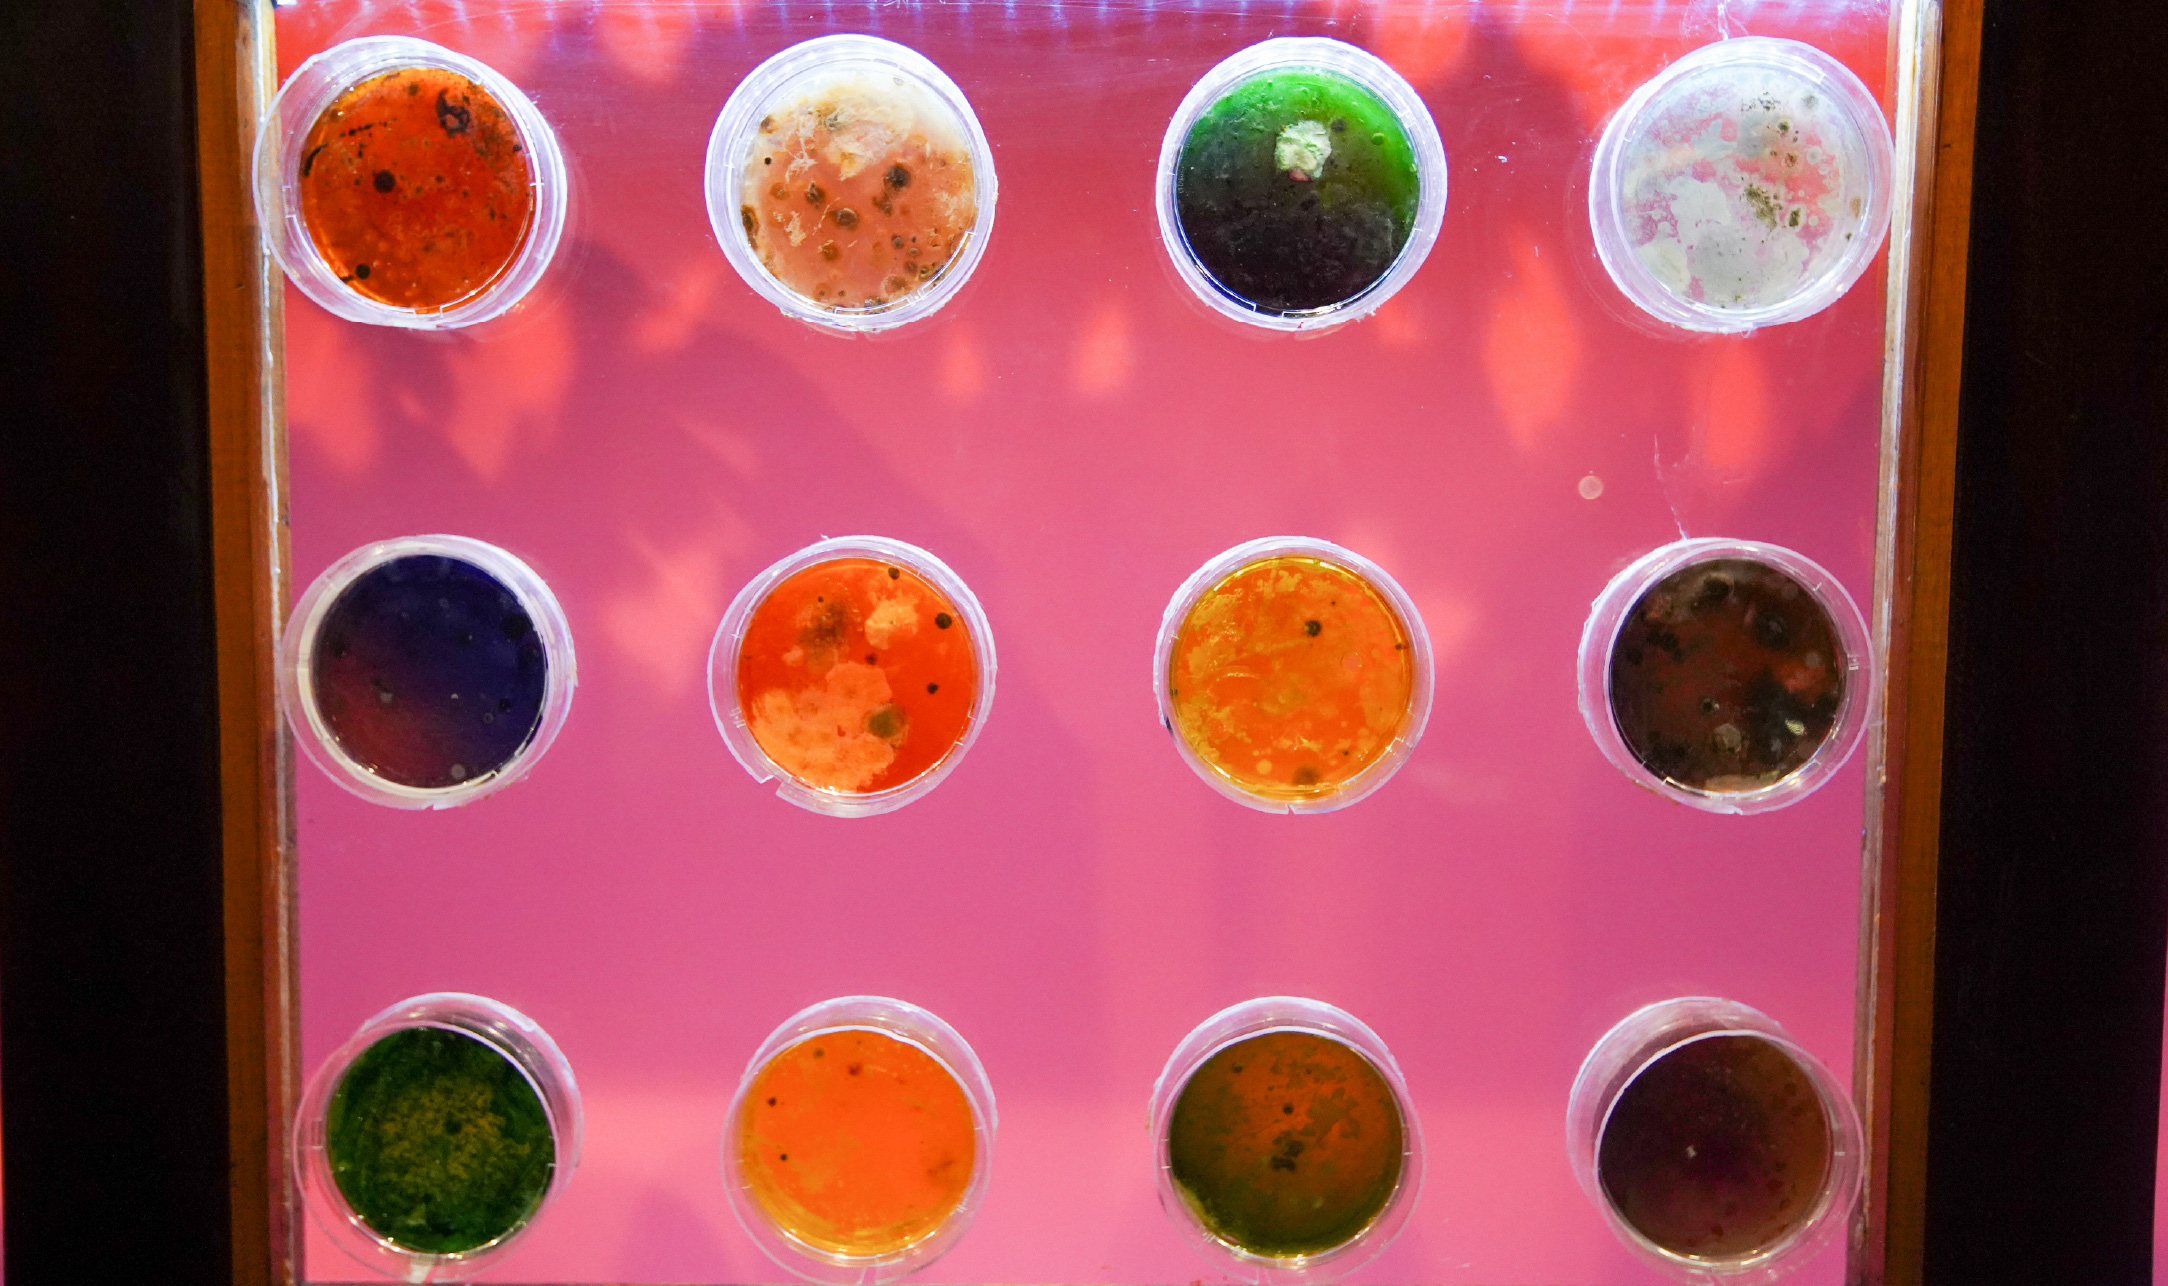
web-17

Earthly Relations and Anthropocentric Awareness: A Study of Knowing Co-Existence by MOTE x Microartmunity
In any narrative that speaks of an earthly relation, what immediately comes to mind is its association with soil, or perhaps the co-existence of humans alongside flora and fauna. Other times, when we speak of the Earth, we think of a familial, almost biological, and collective responsibility: the Earth is beckoned as our mother, and we are her children. And so, in belonging to the Earth, we belong to one another. Throughout all dialogues concerning the Earth, we tend to speak on behalf of ourselves—as humans—because it is within our nature to refer to our own positionality and shared capacities. Isn’t it the most ‘correct’ thing to do to begin from what is embodied within us?
Through Earth Society, ICAD presents a diverse array of art and design works that explore this collective responsibility toward the land we inhabit. Community becomes a central subject, positioning the public to acknowledge the labour of care in tending to earthly relations. Ultimately, the exhibition makes a statement that to care for the Earth (or even to attempt sustainability) is equivalent to caring for one another and for the land that has birthed us. The exhibition reflects broadly on humanity, pointing toward an inherent, almost unavoidable quality of thought: we, as humans, presume ourselves to be the centre of every ecosystem.
However, one piece stood out by reckoning with this anthropocentric tendency, refining the very idea of an earthly relation and asking: can we care for the unknown and unseen? Together, MOTE and Microartmunity birthed an array of works that collectively questioned this through their piece Knowing Co-Existence, a collection of petri-dish art composed of microbial samples gathered across multiple landscapes. Rows of petri dishes sit within a wooden, cabinet-like installation, their colours and textures immediately catching the viewer’s eye. Yellows enmesh with blue-greens; pinks, purples, and whites form gradients of colour beyond man-made comprehension. What is most striking is that none of these colours were planned. “The real artist is nature itself, and we, as humans, are only vessels for its art,” said Nisa of Microartmunity in our interview.The process of art-making was one of collective learning and understanding, as both collaborators came from distinct backgrounds: MOTE are seasoned designers who experiment with pluriversal methodologies, while Microartmunity are scientists deeply engaged with microbiology. Together, they embraced cross-disciplinary work as a site for critical education and inquiry—an approach still rare within Indonesia’s creative landscape. Aulia of MOTE shared that designers often work insularly, their roles tied to servicing industrial interests: “We attempt to traverse the general modality of design and introduce a new practice, where design becomes a form of knowledge-making. There is a tendency for designers to overclaim the purpose of their design, but we believe that design cannot stand on its own. It must learn from other disciplines; it cannot exist in a vacuum of its own interests if it is to fulfill its true function.”
Aulia traced this way of thinking to his university days, where he encountered design’s practical applications in urban planning and met other MOTE members such as Rifki, who shared these beliefs—forming the bedrock of their collective praxis. His connection with Microartmunity emerged from a desire to extend their inquiries into scientific practice. Nisa and Safira explained that their intentions aligned, as Microartmunity began as an artistic collective to make microbiology accessible to a wider public. “Since the pandemic, there’s been a stigma surrounding microbes, linked to the collective fear of COVID. We started this collective to break those barriers and educate audiences about the importance of learning from microbes as living entities.” By blending their distinct approaches, MOTE and Microartmunity have created work that dissolves the boundaries between art and science.
The process of collecting and cultivating microbial samples brought profound reflection among both collectives. Safira noted that the unique imprints of bacterial growth expanded her understanding of the intricate compositions of human landscapes. Cadrilla was struck by the sheer number of bacteria in each sample, recognizing the depth of mutual co-existence. Rifki reflected on the potential danger hidden behind the “funky” beauty of the colours, reminding him of how such unseen entities permeate our daily environments. Risabella was reminded of her childhood fascination with collecting “disgusting” objects; Ihsan drew parallels to his photographic practice, viewing the petri dish as a kind of generative image—a living analogue to AI art, each one forming a singular, organic creation. Nisa described the task as grounding, reminding her of the harmony of cross-species coexistence, since microbes are among the planet’s oldest life forms. For Aulia, the work recalled the overlooked contributions of Indonesian scientists and naturalists, whose deep, embodied relationships to the earth remain underrecognized.
What emerged from the piece was not merely an aesthetic encounter, but a process of collective reflection—an inquiry into what it means to think, feel, and create with the Earth, rather than about it. MOTE and Microartmunity offered a glimpse into what lies beyond language and intention: a reorientation of the human gaze toward the minute, the invisible, and the interdependent. In their collaboration, the idea of “earthly relations” transforms from metaphor into method—an ethics of attention and humility. It reminds us that to know the Earth is not to master it, but to learn, again and again, how to live in dialogue with all that exceeds our understanding.